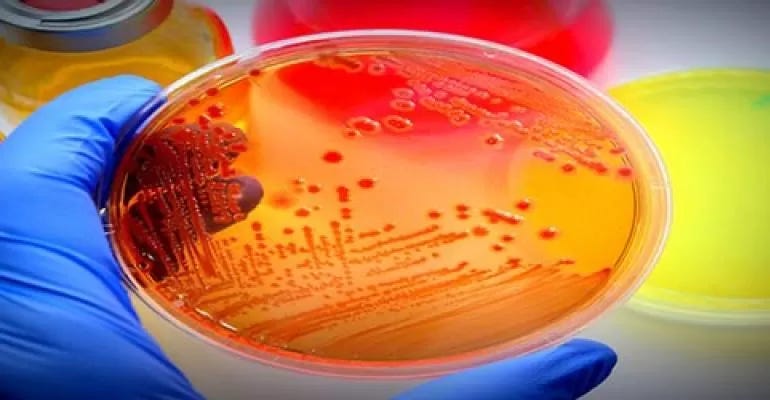

Point of Care Tests in Microbiology: A Clinical Microbiologist’s PerspectivePoint of Care Tests in Microbiology: A Clinical Microbiologist’s Perspective
January 16, 2020
Point of Care Tests (POCT) refers to rapid diagnostic tests performed at or near the consultation of patients to make early decisions about patient management; but this definition continues to evolve. These tests are typically easy to perform and interpret by trained users. POCTs are widely used in the provision of healthcare services in a variety of settings such as general practitioner clinics, hospital clinics and wards, emergency departments, pharmacies etc. Nowadays, some tests can even be performed in the comfort of a patient’s own home.
POCT is well established in some specialities such as clinical chemistry and haematology but historically microbiology tends to lag behind in implementation of POCT. Some of the reasons for this include poor performance of assays, reluctance of physicians to accept POCT results, lack of cost effectiveness and clinical outcome studies, quality control and quality assurance concerns, staff training and interface issues with existing laboratory information systems.
POCT is not new to microbiology. One of the earliest known microbiology POCTs is gram stain for gonorrhoea in sexual health clinics. Due to recent advances in technology the landscape of POCT in microbiology is rapidly evolving. Other factors such as increasing pressure to reduce inappropriate antimicrobial prescribing to tackle antimicrobial resistance, and challenges associated with centralisation of laboratories, for example, increased turn-around time are driving laboratories towards implementation of POCTs. These tests can be broadly divided into tests that detect one or more pathogens and those that do not detect any specific pathogen but provide indirect evidence of infection such as urinary dipstick, C-reactive protein and procalcitonin.
The main benefits of POCT in microbiology are antimicrobial stewardship, infection prevention and control and public health. Other potential benefits include efficient patient flows, reduced length of stay, improved patient satisfaction, and avoidance of unnecessary investigations thus reducing overall healthcare costs.
Antimicrobial Stewardship
Antimicrobial resistance (AMR) is a huge concern and tackling AMR is a priority globally. According to an independent antimicrobial resistance review led by economist Jim O’Neill, more than 700,000 people across the globe die every year due to infections caused by resistant microorganisms and this figure is likely to reach 10 million per year by 2050.
Among the many strategies to tackle AMR, antimicrobial stewardship plays a crucial role. In simple terms, antimicrobial stewardship is about giving the right antibiotic to the right patient at the right dose and right route for the right duration whilst minimising adverse events such as Clostridium difficile and emergence of AMR, thus improving clinical outcomes and reducing healthcare costs. POCTs enable rapid and early diagnosis of infections, which has a significant impact on early and appropriate management of infections.
Until recently, the most commonly used POCTs with impact on improving antibiotic prescribing were those that detected Influenza virus and Group A Streptococcus. These used to be predominantly immunochromatographic tests with variable sensitivities and were popular due to the speed of results, lack of instrumentation/maintenance, and ease of transport/storage making these tests low cost.
In a randomised trial of children presenting with pharyngitis, rapid antigen detection test for Group A Streptococcus was found to decrease the rate of antibiotic prescriptions. Another randomised trial of influenza rapid test in a paediatric emergency department was found to significantly reduce the number of laboratory tests and radiographs ordered and their associated charges, decreased antibiotic use, increased antiviral use, and decreased length of time to discharge.
Lately, technological advances have revolutionised POCTs with adoption of molecular technology with superior sensitivities. In addition, there are now multiplex panels which can detect a large number of viral and bacterial pathogens from respiratory tract specimens. Other POCTs that could potentially impact antimicrobial prescribing include Legionella/Pneumococcal urinary antigen for pneumonia, Chlamydia/Neisseria gonorrhoeae in sexual health clinics and Mycobacterium tuberculosis.
Infection Prevention and Control
Outbreaks caused by dissemination of transmissible infectious agents can be very costly and damage the reputation of an organisation. Microbiology POCTs allow rapid identification of transmissible agents which will enable infection control teams to implement appropriate control measures earlier to prevent further dissemination. POCTs that detect meticillin resistant Staphylococcus aureus (MRSA), Influenza/RSV, Carbapenemase producing enterobacteriaceae are some examples of tests that have the potential to aid infection control teams to prevent outbreaks.
POCTs in MRSA appears to be the most commonly studied but almost all the studies performed rapid MRSA test in the microbiology laboratory rather than on wards or in clinics. Hence, results were not available within 1-2 hours of specimen collection and unsurprisingly some studies did not demonstrate a reduction in transmission or acquisition rates of MRSA. A cluster-randomised cross-over trial in a London hospital where MRSA POCT was performed on four admission wards found no effect on MRSA acquisition rates. They concluded that where compliance with infection prevention and control is high and MRSA carriage is low, POCT has no additional impact on MRSA acquisition rates.
Rapid results alone are not sufficient to prevent dissemination unless preventative measures such as isolation and other infection control measures are in place. Therefore, many factors need to be considered prior to implementing POCTs for infection control purposes. In this article I have not discussed infection control risks related to non-adherence of safe practices in the use of POCTs. Outbreaks of blood borne viruses such as Hepatitis B have been reported due to failures in safe practices such as poor hand hygiene, not wearing gloves, failure to disinfect instruments between patients and sharing of single use equipment.
Public Health
There are many infectious diseases of public health importance. Currently available POCTs for detection of infections such as tuberculosis, Chlamydia/gonorrhoea and HIV can have a significant impact on the control of these diseases. In addition to early diagnosis and treatment, surveillance of these infections play a crucial role in public health management. There is a danger that with POCTs being done in a variety of settings, it can affect public health surveillance, which could lead to failure to recognise outbreaks/epidemics. Thus, it is important that measures are in place to ensure continued surveillance of infectious diseases of public health significance irrespective of where the test is performed. Technology such as smartphone apps and cloud-based data sharing can help achieve this objective.
Future
There remain significant challenges to more widespread use of these tests such as quality control, laboratory oversight, training, competency, interface and data sharing, accreditation clinical outcome and cost effectiveness etc. In 2017, The American Academy of Microbiology published a report that highlighted a number of recommendations in the implementation of POCTs in microbiology. Despite operational challenges, the field of microbiology POCT has made huge strides over the last five years. Future of POCT in microbiology looks very exciting – further innovations and advances in technology will continue to expand repertoire of tests. This can radically change how microbiology services are delivered. Microbiologists should get involved at the earliest opportunity to be a part of this revolution.
References available on request.
